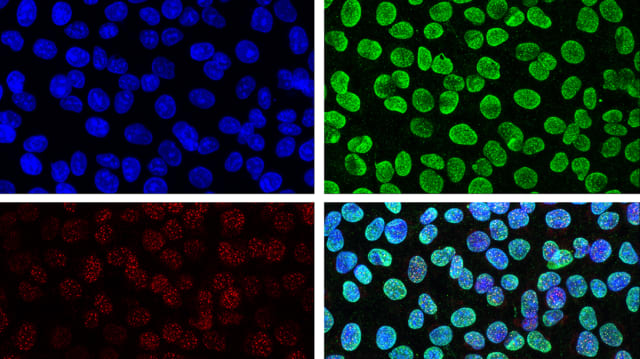
image

Das sind die jungen Medizin-Spitzenforscher der Schweiz
Die Stiftung Pfizer Forschungspreis zeichnete 12 Nachwuchs-Wissenschaftlerinnen und -Wissenschaftler aus, die an Schweizer Unis oder Spitälern forschen.
Loading

Die Stiftung Pfizer Forschungspreis zeichnete 12 Nachwuchs-Wissenschaftlerinnen und -Wissenschaftler aus, die an Schweizer Unis oder Spitälern forschen.

Kostenlose Geräte, Schulung und persönliche Betreuung reichen oft nicht aus: Eine US-Kohortenstudie zeigt, dass viele Hypertonie-Patienten im Alltag keinerlei Messwerte erheben.

Fiona Doetsch vom Biozentrum der Universität Basel erhält für ihre Forschung rund um die Funktionsweise neuraler Stammzellen den mit 500'000 Franken dotierten Louis-Jeantet-Preis für Medizin.

Ab Januar 2026 wird Corina Schütt Leiterin des Science and Translation Hub und Geschäftsführerin des Scientific Steering Board am Universitätsspital Balgrist.

Neue Immuntherapien, innovative Impfstoffe und grosse Studien zu Long Covid und Herzkrankheiten: 2026 könnte für die Medizin zum Jahr entscheidender Durchbrüche werden.

Bence György vom IOB in Basel erhält einen ERC-Grant über rund zwei Millionen Euro, um Gen-Editierungstherapien gegen Sehverlust weiterzuentwickeln.

Bei einer Patientin traten nach einer Darmspiegelung unerwartet schwere Komplikationen auf. Das Bundesgericht stellt nun klar: Die Ärztin aus dem Kanton Aargau kann sich auf die «hypothetische Einwilligung» der Patientin berufen.

Neue Studie aus den USA wirft Fragen auf: Wettbewerb allein garantiert keine besseren Operationsergebnisse.

Während der Ausbildung nimmt das Einfühlungsvermögen von angehenden Ärztinnen und Ärzten tendenziell ab: Das besagt eine neue Studie.